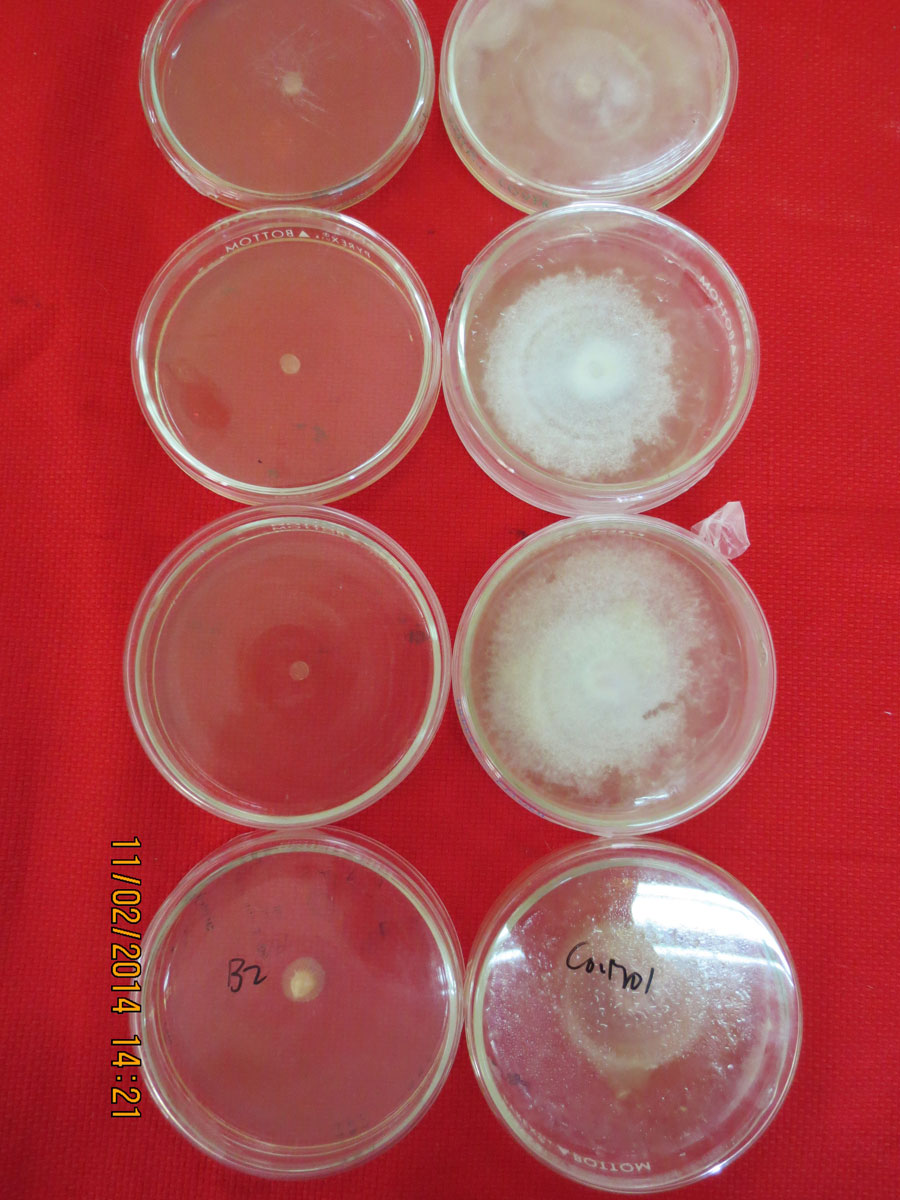
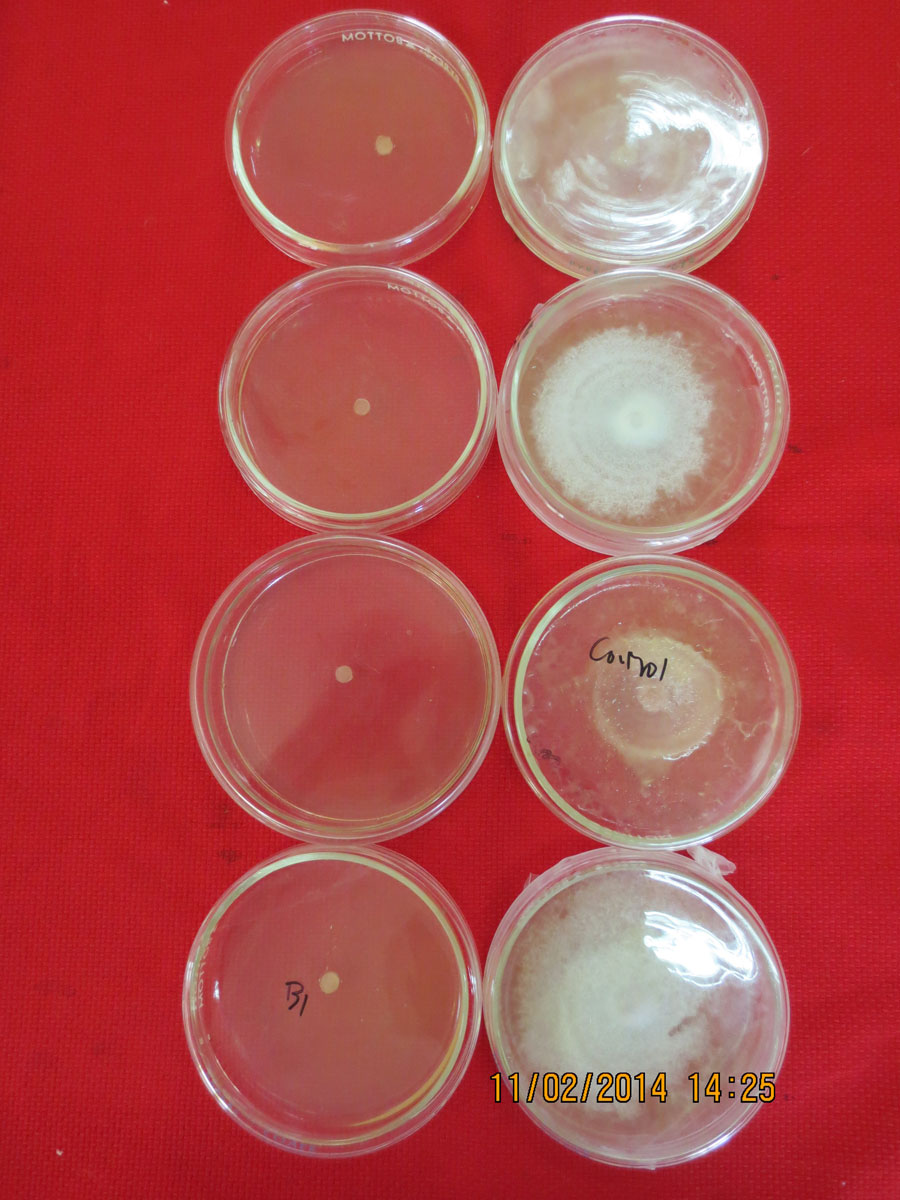
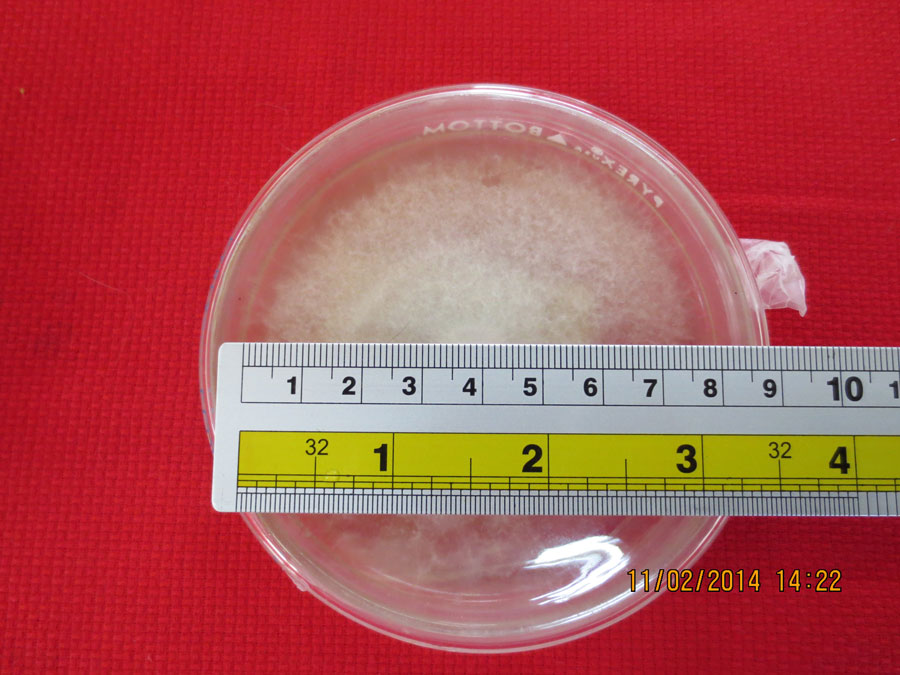

Reports
Directions
NuronBioSafe controls a wide range of diseases on fruit, vegetables and ornamentals. An easy to use, broad-spectrum formula
Fusarium oxysporum f.sp. cubense (Foc) will be isolated from identified infected banana plant. Infected pseudostem strands will be collected and place in blotting paper. A small section (3-5 mm) of the dry infected strands will be plated in quarter strength Potato Dextrose Agar (PDA) amended with streptomycin at 1.2 ml per 240 ml PDA. After 2-4 days Fusarium growth will appear. This will serve as the culture spore of Foc. Bioassay (Poison Food Technique) Seven (7) days old Foc isolates will be used in this test. Mycelial disk (0.5 cm diameter) from the margin of the cultures will be aseptically transferred to the center to the center of the disinfectant-amended PDA using its rate per application. Zone of growth will be compared to the positive control. Degree of inhibition will be computed by subtracting the mycelial growth of the positive check (Foc alone) and the growth of each treatment after 72 hours.
| Treatments | Average growth (mm) | Degree of inhibition (mm) | Degree of Efficacy | Cost per Liter |
| Biosafe 1 | 0 mm | 59 mm | VE | Â |
| Biosafe 2 | 10 mm | 49 mm | VE | Â |
| Positive Control (Pure Culture) | 59 mm | Â | Â | Â |
*Note statistical analysis to follow.
| Degree of Growth Inhibition (mm) | Degree of Efficacy |
| 0.1-10.0 | Not Effective (NE) |
| 10.1-20.0 | Moderately Effective (ME) |
| 20.1-30.0 | Effective (E) |
| 30.1-above | Very Effective (VE) |
Table 1 shows the average growth of Bioafe 1 and 2 compare to the positive control or pure Foc isolate. As shown in Table 1 no growth of Foc was observed in Biosafe 1 as compare to Biosafe 2 which has an average of 10 mm. This means that, Biosafe 1 can inhibit the growth of Foc in the laboratory at 75 ml/liter. Using Biosafe 2, there was growth of Foc at 75ml/ liter.
Figure 1. Biosafe 2 at 75 ml compare to control.

Figure 3. Biosafe 1 and 2 compare to control.

Figure 3. Biosafe 1 and 2 compare to control.

Figure 3. Biosafe 1 and 2 compare to control.